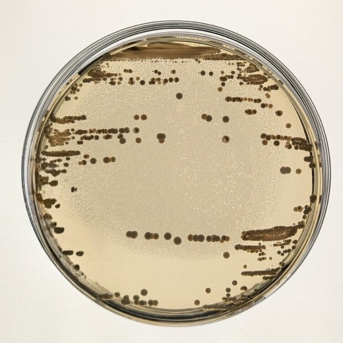
Imagen de placas de cultivo con cepas clínicas de 'Klebsiella pneumoniae'. CNB-CSIC

Hallan un mecanismo esencial en la muerte de neuronas motoras en la ELA
Un equipo del Instituto de Neurociencias (IN), centro mixto del Consejo Superior de Investigaciones Científicas (CSIC) y la Universidad Miguel Hernández (UMH), ha comprobado que un sistema celular de “limpieza selectiva” de proteínas, conocido como autofagia mediada por chaperonas, reduce de forma notable su actividad en pacientes con esclerosis lateral...